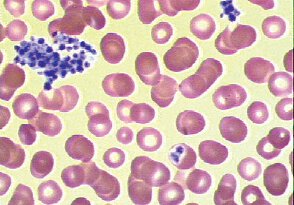

A 50-year-old woman is evaluated in the ICU for painful changes in her fingers, as shown, following placement of a right radial artery catheter 5 days ago. She has been receiving heparin therapy since admission. Her platelet count was normal on admission but it is now 35,000/μL (35 × 109/L).

Which of the following is the most likely diagnosis?
A. Antiphospholipid antibody syndrome
B. Disseminated intravascular coagulation
C. Heparin-induced thrombocytopenia and thrombosis
D. Thrombotic thrombocytopenic purpura
C. Heparin-induced thrombocytopenia and thrombosis
The most likely diagnosis is heparin-induced thrombocytopenia and thrombosis (HITT). Up to 2% of patients treated with heparin develop heparin-induced thrombocytopenia, and approximately 30% of such patients develop HITT. In patients with HITT, venous thrombi occur two- to fourfold more often than do arterial thrombi, although in patients with underlying arterial disease this ratio is reversed. Thrombi have a propensity to form in areas of vascular damage, such as in vessels in which indwelling catheters have been placed, as in this patient.
In patients with suspected heparin-induced thrombocytopenia, use of the 4T score is recommended to guide clinical decisions and management.
Heparin should be discontinued in patients with suspected heparin-induced thrombocytopenia (HIT) and an intermediate or high 4T score, and HIT laboratory testing should be obtained; in most cases, a non-heparin anticoagulant should be initiated.
A 52-year-old man is evaluated after hospital discharge for total knee arthroplasty. In the recovery room following the procedure, he was reintubated because of hypoxemia, which was then completely resolved. The postintubation chest radiograph was normal. Hypoxemia did not return following extubation 24 hours later, and oxygenation was normal at discharge on hospital day 4. He also has hypertension. Medications are lisinopril and short-term apixaban for postarthroplasty venous thromboembolism prophylaxis.
On physical examination, vital signs are normal. BMI is 31. Neck circumference is 42 cm (16.5 in). He has a low-lying soft palate. Lung and heart examinations are normal.
Which of the following is the most likely cause of the hypoxemia?
A) Aspiration pneumonia
B) Obstructive sleep apnea
C) Pulmonary edema
D) Pulmonary embolism
B) Obstructive sleep apnea
Obstructive sleep apnea may be clinically recognized for the first time after a procedure that entails general anesthesia and/or narcotics and may manifest as repeated episodes of postoperative hypoxemia but may also present as frank respiratory failure.
A 73-year-old woman is evaluated for a 3-week history of proximal muscle weakness.
Skin findings are shown.

Which of the following is the most likely diagnosis?
A) Dermatomyositis
B) Hypothyroid myopathy
C) Immune-mediated necrotizing myopathy
D) Inclusion body myositis
A) Dermatomyositis
Typical cutaneous involvement of dermatomyositis is the Gottron rash (Gottron papules and Gottron sign), consisting of erythematous to slightly elevated, slightly scaly, violaceous papules and plaques over the metacarpophalangeal and proximal interphalangeal joints, as seen in this patient. These findings may also be found overlying the elbows, knees, and/or feet. This type of cutaneous involvement of dermatomyositis can be virtually pathognomonic.
A 72-year-old woman is evaluated in the emergency department for a 1-hour history of left-sided weakness. The patient has hypertension and dyslipidemia. She has had no recent surgery or history of gastrointestinal, genitourinary, or intracranial bleeding. Medications are amlodipine and atorvastatin.
On physical examination, blood pressure is 168/92 mm Hg; the remaining vital signs are normal. Oxygen saturation is 97% with the patient breathing ambient air. Left facial weakness, dysarthria, decreased sensation to pinprick on the left side of the body, and left arm and leg drift are noted. A bedside swallow examination is positive for dysphagia. Her score on the National Institutes of Health Stroke Scale is 6. Neurologic examination reveals a normal mental status. The remainder of the physical examination is normal.
A CT scan of the head without contrast shows no intracerebral hemorrhages or early hypodensities.
Which of the following is the most appropriate treatment?
A) Intravenous alteplase
B) Intravenous low-molecular-weight heparin
C) Intravenous nicardipine
D) Oral aspirin
A) Intravenous alteplase
She has an acute ischemic stroke and is seen within 3 hours of onset of symptoms, which include the disabling neurologic feature of hemiparesis involving the left face, left arm and leg, and left-sided sensation. Her National Institutes of Health Stroke Scale score is 6. The patient does not have any absolute or relative exclusion criteria for thrombolysis, including recent surgery, prior or current intracranial hemorrhage, extensive hypodensity on imaging, or blood pressure above the target of 185/110 mm Hg. The benefits of intravenous alteplase in acute ischemic stroke, including the lower likelihood of neurologic disability at 3 months poststroke, are generally thought to outweigh the small risk of hemorrhage.
Acute administration of anticoagulation in ischemic strokes (whether related to atrial fibrillation or not) does not reduce the short-term risk of recurrent stroke and increases the risk of hemorrhage into the territory of cerebral infarction (hemorrhagic conversion). Low-molecular-weight heparin (Option B) is not indicated.
Treatment of blood pressure with antihypertensive agents (such as nicardipine [Option C]) is not indicated in acute ischemic stroke unless the blood pressure of a patient eligible for alteplase is greater than 185/110 mm Hg (or is greater than 220/120 mm Hg for patients who are not candidates for thrombolysis). If intravenous alteplase is administered, target blood pressure is less than 180/105 mm Hg.
Aspirin (Option D) should be held for 24 hours after thrombolysis to reduce the risk of intracerebral hemorrhage. If this patient were not a candidate for thrombolysis, aspirin administered within 48 hours is indicated in order to reduce the risk of subsequent stroke but should not be administered now given the positive dysphagia screen and the need for thrombolytic therapy.
Name the element used to make luminescent clocks and paint as below, which eventually was found to cause several health effects including necrosis of the jaw.

Radium
A 31-year-old woman is evaluated for asymptomatic thrombocytopenia. She is 10 weeks pregnant.
Peripheral blood smear is shown.
Which of the following is the most likely diagnosis?
A) Gestational thrombocytopenia
B) HELLP (Hemolysis, Elevated Liver enzymes, Low Platelets) syndrome
C) Preeclampsia
D) Pseudothrombocytopenia
D) Pseudothrombocytopenia
Pseudothrombocytopenia is an artifact in which platelets agglutinate and the clumped platelets are not recognized by automated blood counters. In this situation, the large platelet clumps (arrow) may be seen on the stained blood film. These clumps occasionally adhere to neutrophils but may also be unassociated with any other cell types.
The first step in the evaluation of thrombocytopenia is to review the peripheral blood smear and confirm the platelet count.
Pseudothrombocytopenia occurs when patients have antibodies to ethylenediaminetetraacetic acid, causing platelets to clump together in vitro; an accurate count can be obtained from blood drawn in citrate or heparin.
A 59-year-old woman is evaluated for hypersomnolence and dyspnea without cough. She does not smoke cigarettes.
Vital signs are normal. BMI is 47. Respirations are shallow. She falls asleep several times during the examination. Signs of right-sided heart failure are present. The neurologic examination is unremarkable.
Bicarbonate 30 mEq/L (30 mmol/L)
Arterial blood gases (ambient air):
pH 7.31
PCO2 62 mm Hg (8.3 kPa)
PO2 59 mm Hg (7.9 kPa)
Which of the following is the most likely diagnosis?
A) Central sleep apnea
B) Chronic inflammatory demyelinating polyradiculoneuropathy
C) COPD
D) Obesity hypoventilation syndrome
D) Obesity hypoventilation syndrome
OHS is defined as the presence of obesity (BMI ≥30) and daytime arterial hypercapnia (PCO2 ≥45 mm Hg [5.9 kPa]) in the absence of other causes of alveolar hypoventilation. The vast majority of people with OHS also have obstructive sleep apnea (OSA). OHS is typically diagnosed during an episode of acute-on-chronic hypercapnic respiratory failure, characterized by dyspnea and somnolence. Frequent comorbidities include heart failure and pulmonary hypertension. This patient has severe obesity (BMI >40) and an elevated carbon dioxide level (62 mm Hg [8.3 kPa]) during wakefulness, the defining characteristics of OHS. Although OHS is a diagnosis of exclusion and further evaluation is warranted, it is the most likely cause of hypercapnic respiratory failure in this patient with no history of chronic lung disease. To establish the diagnosis, evaluation should exclude other causes of hypoventilation, including COPD, restrictive chest wall deformity, severe hypothyroidism, neuromuscular disease, and central hypoventilation syndromes. Positive pressure ventilation is often effective for treatment of hypoventilation. Weight loss, possibly including bariatric surgery, is recommended.
Central sleep apnea (Option A) is a sleep-associated breathing disorder with decreased central respiratory drive. Patients typically present with excessive daytime sleepiness. Central sleep apnea is most commonly found in older men with other comorbid conditions, such as heart failure or opioid use. It is not a hypoventilation syndrome, as seen in this patient, and arterial blood gases generally reveal normocapnia or slight hypocapnia.
Chronic inflammatory demyelinating polyradiculoneuropathy (CIDP) (Option B) is a potentially treatable autoimmune neuropathy. CIDP often presents with a progressive or relapsing symmetric proximal and distal weakness and sensory symptoms with diffuse areflexia. Its temporal course is often subacute, with progression after 8 weeks of onset. Atypical forms include multifocal asymmetric and distal symmetric variants, but respiratory failure is rare. This patient has no findings suggestive of CIDP.
Long-standing, severe COPD (Option C) may lead to carbon dioxide retention and hypercapnia, but COPD is less likely in this patient given the absence of risk factors and audible wheezing, cough, or sputum production.
A 73-year-old man is evaluated for a 3-year history of progressive weakness. He has a 7-year history of hyperlipidemia and hypertension treated with atorvastatin and lisinopril.
On physical examination, vital signs are normal. Symmetric proximal and distal weakness in both arms is noted. Hip flexor strength is diminished, and he has a waddling gait. Otherwise, lower extremity strength is normal. Upper extremity examination is notable for atrophy of the forearm muscles and a weak grip. No muscle tenderness, joint swelling, edema, or rash is observed.
Serum creatine kinase level is 310 U/L. Erythrocyte sedimentation rate, serum aminotransferase levels, and thyroid-stimulating hormone level are normal.
Which of the following is the most likely diagnosis?
A) Inclusion body myositis
B) Polymyositis
C) Statin myopathy
D) Systemic lupus erythematosus
A) Inclusion body myositis
Inclusion body myositis is an uncommon cause of weakness generally seen in older adults, characterized by a slow, insidious onset. It can be distinguished clinically from polymyositis by the involvement of distal muscle groups in addition to proximal muscle groups. Weakness in finger flexors and atrophy of forearm muscles are characteristic features. Muscle distribution is usually but not always symmetric. Up to half of patients with inclusion body myositis have cricopharyngeal muscle involvement, leading to dysphagia and increased risk for aspiration. Patients with inclusion body myositis can have elevated serum creatine kinase levels, but elevations are usually more modest, less than 10 times the upper limit of normal, as compared with other forms of idiopathic inflammatory myopathies in which serum creatine kinase levels are generally higher. A muscle biopsy can help to confirm the diagnosis but is not needed when clinical features are characteristic.
Polymyositis (Option B) can also present with progressive muscle weakness. However, it generally progresses more rapidly over weeks or months and involves only the proximal muscles. Activities such as arising from a chair, climbing stairs, and lifting objects above shoulder height are typically affected. Onset over several years with a more modest degree of weakness, as seen in this patient, would be unusual in polymyositis. In addition, polymyositis would not be expected to cause weakness of the hands or the distal arm muscles.
Statins are generally safe and well tolerated. They can cause asymptomatic, dose-related elevations in aminotransferase levels in approximately 1% of patients, but liver injury occurs in less than 0.001% of patients. The incidence of statin-associated muscle symptoms is no greater than 1%, and the incidence of myopathy (Option C) and rhabdomyolysis is less than 0.1%. However, some patients can have muscle symptoms from statin therapy without an elevation in serum creatine kinase levels, and it can then be difficult to be certain whether muscle symptoms are due to statin therapy. The patient's prolonged course, minor serum creatine kinase elevation, and muscle weakness distribution are more characteristic of inclusion body myositis than statin myopathy.
A 34-year-old woman is hospitalized for right-sided visual loss of 2 days' duration. She has no headache, eye pain, or neck pain. She has had two prior pregnancies without complications. She has no other symptoms and is otherwise well.
On physical examination, vital signs are normal. Right visual field deficit in both eyes is observed. Pupils are equal in size and are reactive to light; she has full eye movements.
Complete blood count, coagulation profile, and C-reactive protein level are normal.
CT scan of the head shows a left occipital infarct. Magnetic resonance angiogram of the head and neck and ECG are normal.
Which of the following is the most appropriate diagnostic test to perform next?
A) Catheter angiography
B) Lumbar puncture
C) Transesophageal echocardiography
D) Transthoracic echocardiography with agitated saline
D) Transthoracic echocardiography with agitated saline
The patient had an embolic stroke, given the location in the occipital lobe and normal findings on vascular imaging. Leading causes of stroke in young patients with no risk factors include cervicocephalic artery dissection, a hypercoagulable state, vasculitis, and embolism from a patent foramen ovale. This patient does not have a headache, and the magnetic resonance angiogram was normal, making a dissection very unlikely. Her lack of other systemic symptoms, including fevers, rash, and joint pain, makes vasculitis less likely. A primary hypercoagulable state remains possible and should be investigated, although it is less likely given her normal laboratory values and prior pregnancies without complications. TTE with agitated saline injection can reveal a right-to-left shunt, is less invasive than other cardiac imaging, and is indicated in younger patients with stroke without other risk factors. Agitated saline with a TTE is not indicated in patients older than 45 to 50 years because a patent foramen ovale is less likely to be causally related to symptoms in that age group.
Name the four ancient humors
Blood (enthusiastic and social)
Yellow bile (independent and decisive)
Black bile (introverted and sad)
Phlegm (relaxed and easygoing).
A 42-year-old woman is evaluated in the emergency department for 2-day history of headache, dizziness, and easy bruising. Her medical history is otherwise unremarkable, and she takes no medications.
On physical examination, temperature is 38.0 °C (100.4 °F), blood pressure is 150/98 mm Hg, pulse rate is 104/min, and respiration rate is 16/min. A neurologic examination is normal. She has no lymphadenopathy or organomegaly. Petechiae are noted on both legs.
Laboratory studies:
Haptoglobin - Undetectable
Hemoglobin - 8.2 g/dL (82 g/L)
Leukocyte count - 10,200/μL (10.2 × 109/L)
Platelet count - 8000/μL (8 × 109/L)
Reticulocyte count - 5% of erythrocytes
Creatinine - 1.1 mg/dL (97.2 μmol/L)
Peripheral blood smear is shown.

Which of the following is the most appropriate treatment?
A) Caplacizumab
B) Intravenous nitroprusside
C) Plasma exchange plus prednisone and rituximab
D) Platelet transfusion
E) Plasmapheresis with normal saline and 5% albumin replacement
C) Plasma exchange plus prednisone and rituximab
She has thrombotic thrombocytopenic purpura (TTP) based on the presence of thrombocytopenia and microangiopathic hemolytic anemia (MAHA), with supporting features of fever and headache. Acquired TTP is most often caused by production of an autoantibody that leads to a deficiency in the metalloprotease ADAMTS13, which is responsible for cleaving high-molecular-weight von Willebrand factor (vWF) multimers. An excess of high-molecular-weight vWF multimers causes platelet clumping in the microvasculature that leads to platelet consumption and MAHA. Plasma exchange with fresh frozen plasma is a crucial component of therapy that will remove the autoantibody and replace the deficient ADAMTS13. Prednisone is used to decrease continued autoantibody production. Rituximab further suppresses autoantibody production and the risk of recurrence.
Caplacizumab is a monoclonal antibody that binds to vWF and blocks the interaction of vWF to platelets (Option A). It is approved as an ancillary treatment for TTP in severe cases but would not be initiated before a trial of plasma exchange, glucocorticoids, and rituximab.
Although she has a low platelet count with evidence of petechiae, platelet transfusion should not be performed for a patient with TTP without life-threatening bleeding because it increases the risk of arterial thrombosis (Option D).
Performing plasmapheresis with non-plasma replacement, such as saline and albumin, will remove the autoantibody but does not correct the ADAMTS13 deficiency (Option E). Plasma exchange and immunosuppressive therapy are crucial to remove the autoantibody, replace the deficient ADAMTS13, and prevent the formation of new autoantibody.
A 42-year-old man is evaluated at a follow-up appointment. He underwent polysomnography 6 weeks ago because of suspected obstructive sleep apnea. The study showed moderate obstructive sleep apnea (apnea-hypopnea index 20) that was controlled with continuous positive airway pressure (CPAP). Although daytime alertness has improved with CPAP, the apparatus is cumbersome to transport on his frequent business trips. At his last visit, the physical examination was normal except for a BMI of 34.
The patient is enrolled in a supervised weight loss program and has started to exercise.
Which of the following is the most appropriate treatment?
A) Hypoglossal nerve stimulator
B) Maxillomandibular advancement surgery
C) Oral appliance
D) Uvulopalatopharyngoplasty
C) Oral appliance
This patient has symptomatic obstructive sleep apnea (OSA) of moderate severity. OSA severity improves with weight loss, so all patients with overweight or obesity should be counseled accordingly. In minimally symptomatic patients with mild OSA, weight loss might be preferred therapy. Additional measures that may help mild OSA include reducing alcohol intake before bedtime, avoiding sedating medications (benzodiazepines, opioids), and avoiding a supine posture if OSA is position dependent. Although CPAP improves symptoms and is generally the preferred treatment for OSA, patient preference or intolerance to CPAP should prompt consideration of other treatments. Oral appliances increase upper airway caliber primarily by exerting traction to advance the mandible. Randomized controlled trials of these appliances have demonstrated good control of mild to moderate OSA and improvement in symptoms such as daytime sleepiness.
A hypoglossal nerve stimulator (Option A) is implanted in the chest wall and synchronizes with the respiratory cycle to contract the tongue muscles during inspiration. A multicenter clinical trial demonstrated its efficacy in OSA, including severe disease; however, there are criteria for patient selection, and the procedure is not recommended for patients with a BMI greater than 32. This patient's BMI of 34 would exclude him from candidacy. Although hypoglossal nerve stimulation is efficacious in select patients, it is invasive and more costly than CPAP and oral appliances and is not the best initial option for this patient.
Case series have demonstrated significant improvements in apnea-hypopnea index following maxillomandibular advancement surgery (Option B), but in most patients this procedure would not be considered a primary treatment. Evidence supporting upper airway surgical procedures to treat OSA is limited. Patient selection is not standardized, and neurocognitive outcomes are unknown or inconsistent. Referral to a sleep surgeon for upper airway surgery should be considered for patients with a BMI <40 who are intolerant of positive airway pressure therapy, but this patient tolerates the CPAP.
Literature on uvulopalatopharyngoplasty (Option D), a soft palatal procedure, shows only limited improvements in apnea-hypopnea index. Trial data are beginning to emerge, but at this time, the procedure should generally not be recommended for primary treatment of OSA.
A 50-year-old woman is evaluated for a 6-month history of progressive difficulty getting out of a chair and raising her arms above her head. She has a 10-year history of Raynaud phenomenon and gastroesophageal reflux. Current medications are omeprazole and acetaminophen.
On physical examination, vital signs are normal. Fingers are puffy bilaterally, without digital ulcers or skin thickening. Neurologic examination shows bilateral proximal muscle weakness; distal muscle strength in upper and lower extremities is normal bilaterally. The remainder of the examination is normal.
Laboratory studies:
Complete blood count- Normal
C3 complement - Normal
C4 complement - Normal
Creatine kinase - 2000 U/L
Antinuclear antibodies - Strongly positive
Anti–U1-ribonucleoprotein antibodies - Positive
Anti-Ro/SSA antibodies - Negative
Anti-La/SSB antibodies - Negative
Anti–smooth muscle antibodies - Negative
Anti–double-stranded DNA antibodies - Negative
Urinalysis - Normal
Which of the following is the most likely diagnosis?
A) Mixed connective tissue disease
B) Rheumatoid arthritis
C) Systemic lupus erythematosus
D) Undifferentiated connective tissue disease
A) Mixed connective tissue disease
MCTD is an overlap syndrome that includes clinical features of systemic sclerosis, systemic lupus erythematosus, and/or inflammatory myositis. It is associated with anti–U1-ribonucleoprotein (RNP) antibodies. Clinical features may present sequentially over time, as in this patient presenting with proximal muscle weakness consistent with inflammatory myositis. Raynaud phenomenon is common in patients with MCTD. Gastroesophageal reflux may be due to esophageal dysmotility, a systemic sclerosis–like condition; the presence of diffusely puffy fingers is also a common finding in early systemic sclerosis. Treatment of MCTD is based on the specific organ system involved. The presence of new myositis requires treatment with immunosuppressive medication.
A 61-year-old woman is evaluated for sudden paralysis of the right side. A CT scan without contrast taken 7 hours after symptom onset (left panel) and 24 hours after symptom onset (right panel) are shown.

Which of the following is the most likely diagnosis?
A) Herpes simplex encephalitis
B) Intracerebral hemorrhage
C) Ischemic stroke
D) Subarachnoid hemorrhage
C) Ischemic stroke
The most likely diagnosis is ischemic stroke. This patient's initial CT scan (left panel) is unremarkable, showing no evidence of hemorrhagic stroke, which would appear as a white density within the gray brain tissue, or infarction. The initial noncontrast head CT in ischemic stroke is often normal, but within 24 to 48 hours after onset of stroke symptoms, the ischemic brain tissue becomes edematous, resulting in a hypodense region on CT scan, as seen on this patient's follow-up CT scan (right panel). If the edema is significant, a mass effect may be seen with shift of midline structures (as is seen on the follow-up scan) and obliteration of the basilar cisterns. CT is insensitive for the presence of herpes simplex encephalitis, but temporal lobe hypodensities may be seen in severe cases.
The study of the conformation of the skull as indicative of mental faculties and traits of character, especially according to the hypotheses of Franz Joseph Gall (1758–1828), a German doctor, and such 19th-century adherents as Johann Kaspar Spurzheim (1776–1832) and George Combe (1788–1858).
In other words, an individual's character and abilities could be deduced from the size and shape of various bumps on the head.
Phrenology
A 32-year-old man is evaluated for easy bruising. He has no other medical problems; takes no medications, recreational drugs, or supplements; and does not drink alcohol.
On physical examination, vital signs are normal. Two small ecchymoses are noted on the left thigh; he also has one small bruise on the right upper arm. No petechiae are visible. He has no lymphadenopathy or hepatosplenomegaly.
Laboratory studies:
Hemoglobin - 14.5 g/dL (145 g/L)
Leukocyte count - 5500/μL (5.5 × 109/L)
Mean corpuscular volume - 85 fL
Platelet count - 44,000/μL (44 × 109/L)
Reticulocyte count - 1.2% of erythrocytes
Creatinine - 0.7 mg/dL (61.9 μmol/L)
Urinalysis- Normal
Peripheral blood smear is unremarkable.
Which of the following are the most appropriate diagnostic tests?
A) Antinuclear antibodies and complement level
B) Antiplatelet antibodies and direct antiglobulin test
C) HIV and hepatitis C virus
D) Vitamin B12 and folate levels
C) HIV and hepatitis C virus
This patient has acute immune thrombocytopenic purpura (ITP). The initial evaluation for patients with ITP should include testing for HIV and hepatitis C virus because thrombocytopenia may be the initial presenting sign in these infections. Patients with HIV infection may have ITP independent of HIV viral load or CD4 cell count and may be otherwise asymptomatic. Although many patients with hepatitis C have symptoms, they are nonspecific and may not be directly related to the viral infection but rather to associated comorbid conditions. Testing for Helicobacter pylori may also be reasonable if the patient is from an endemic region.
Testing for systemic lupus erythematosus would be appropriate if the patient reported symptoms such as arthralgia, pleuritic chest pain, photosensitivity, or rash or had other cytopenias or evidence of kidney disease. Because none of these is present, antinuclear antibody and complement level testing is not necessary (Option A).
Although the pathogenesis of ITP is presumably related to autoantibody-mediated platelet destruction, the current methodology for antiplatelet antibody testing is not sensitive or specific enough to assist in the diagnosis. The patient also has no signs of concurrent hemolysis (normal hemoglobin level, reticulocyte count), so a direct antiglobulin test is not needed (Option B).
Vitamin B12 and folic acid are needed for normal hematopoiesis (Option D). However, isolated thrombocytopenia would be an unusual manifestation of these vitamin deficiencies. Although some patients with vitamin B12 deficiency are not anemic, they are apt to have macrocytosis, which is absent in this patient, as shown by the normal mean corpuscular volume. The patient has a normal leukocyte count, and no hypersegmented polymorphonuclear cells are noted on his peripheral blood smear, so a vitamin deficiency is unlikely to be the cause of his thrombocytopenia.
A 38-year-old woman is evaluated for a 3-month history of difficulty falling asleep most nights of the week. Symptoms began after she started a new job with increased responsibilities. She typically goes to bed around 10 PM, and it can take up to 2 hours for her to fall asleep. Once asleep, she sleeps through the night and wakes around 6 AM. She is distressed and anxious about not being able to fall asleep and finds it difficult to concentrate on her work during the day because of fatigue. She reports no depressed mood, generalized anxiety, or anhedonia. She has no other medical problems and takes no medications.
Which of the following is the most appropriate treatment?
A) Cognitive behavioral therapy
B) Lorazepam
C) Melatonin
D) Sleep hygiene education
E) Zolpidem
A) Cognitive behavioral therapy
This patient has chronic insomnia, which is diagnosed by the presence of symptoms that (1) cause substantial functional distress or impairment; (2) occur at least 3 nights per week for at least 3 months; and (3) are not associated with other sleep, medical, or mental disorders. Several guidelines recommend cognitive behavioral therapy for insomnia (CBT-I) as first-line therapy for insomnia. This multicomponent treatment includes cognitive therapy (to address maladaptive beliefs and expectations about sleep), educational interventions (such as sleep hygiene), and behavioral interventions (such as sleep restriction therapy, stimulus-control therapy, and relaxation techniques). CBT-I may be delivered in various formats, such as individual or group therapy, web-based modules, or written materials. It provides significant value over pharmacologic-driven approaches and carries little risk for adverse effects. Pharmacologic therapies should be reserved for patients who do not improve with nonpharmacologic treatments.
Benzodiazepines, such as lorazepam (Option B), induce sedation by activating inhibitory γ-aminobutyric acid (GABA) receptors. These drugs decrease sleep latency and have a sleep-promoting effect. Benzodiazepines are not recommended for insomnia because of the risks for rebound insomnia, addiction, and oversedation.
Over-the-counter melatonin (Option C) may be effective for circadian rhythm disruptions, but data supporting its efficacy are poor.
Sleep hygiene education (Option D) includes instruction on factors that may impair sleep (such as alcohol or caffeine intake before bed) or improve sleep (such as instituting a regular bedtime routine). Although a component of CBT-I, sleep hygiene education has not been shown to be effective as a standalone therapy for chronic insomnia.
Nonbenzodiazepine GABA-receptor agonists are typically more selective in their activity at the GABA receptor. These agents, including zolpidem (Option E), have a rapid onset of action and short half-life, making them better choices for patients with difficulty initiating sleep. There is potential for prolonged impaired driving skills, somnolence, and amnesia with their use, and there are few data on the long-term safety or efficacy of these agents. Reports of serious or fatal injuries associated with complex sleep behaviors prompted the FDA to issue a boxed warning for zolpidem.
A 56-year-old man is evaluated for 7 weeks of progressive muscle weakness and myalgia. He does not have sensory symptoms. He has dyslipidemia treated with atorvastatin.
On physical examination, vital signs are normal. There is no rash. Examination reveals proximal limb weakness and diffuse hyporeflexia. Proximal muscles are tender to palpation. The remainder of the neurologic examination is normal. Serum creatine kinase level and blood C-reactive protein levels are normal.
Which of the following is the most likely diagnosis?
A) Drug-induced myopathy
B) Inclusion body myositis
C) Myasthenia gravis
D) Polymyositis
A) Drug-induced myopathy
This patient has evidence of progressive proximal muscle weakness, myalgia, and hyporeflexia consistent with a subacute painful myopathy. Drug-induced myopathy (Option A) secondary to atorvastatin is the most likely diagnosis. Drug-induced myopathy is an important and treatable cause of subacute myopathy. Statins and other lipid-lowering agents, including fibrates such as gemfibrozil and fenofibrate, can cause muscle-related symptoms that range from asymptomatic hyperCKemia and mild myalgia to progressive myopathy and, in rare cases, rhabdomyolysis. Concomitant use of these agents; age older than 65 years; use of higher doses of statins; and coexisting kidney disease, liver disease, or hypothyroidism can increase the risk for myopathy. Serum creatine kinase (CK) levels can be normal, mildly, or highly elevated in statin myopathy. The lipophilic statins (simvastatin, atorvastatin, and lovastatin) have a higher propensity to cause myopathy than the hydrophilic agents (pravastatin and rosuvastatin). The risk for myopathy increases with higher dosages, the addition of fenofibrate or gemfibrozil, and the addition of cytochrome P450 3A4 isozyme inhibitors. Other toxins and drugs known to cause toxic myopathy include alcohol, cyclosporine, amiodarone, hydroxychloroquine, antiretroviral drugs, glucocorticoids, and immune checkpoint inhibitors.
Inclusion body myositis (Option B) is a uniformly insidious condition and is usually easily distinguishable from the other inflammatory myopathies because of its very slow onset and pattern of muscle involvement. Patients typically report a history of preexisting weakness averaging 5 years. Although proximal muscle involvement is present, distal muscle involvement also occurs, distinguishing it from polymyositis and dermatomyositis. Muscle distribution is typically symmetric, but asymmetry may occur. On physical examination, muscle weakness and atrophy are often present in the hip flexors, quadriceps, finger flexors, and forearm flexors. Serum CK levels are elevated.
Myasthenia gravis (MG) (Option C) presents with fluctuating weakness of extraocular, bulbar, and proximal limb muscles and is painless. In this case, the progressive course and muscle pain are inconsistent with MG.
The symptoms of polymyositis (Option D) usually progress slowly over months, although a more rapid onset may occur. Progressive, symmetric, proximal muscle weakness is the classic and dominant feature. Activities such as arising from a chair, stair climbing, and lifting objects above shoulder height are typically affected. Neck flexors are also commonly involved. Muscle pain and tenderness, if present, are mild. Muscle atrophy is a late manifestation. Weakness of respiratory muscles may also occur. Serum CK is almost universally elevated in polymyositis and is a marker of muscle damage.
A 74-year-old woman has a follow-up evaluation of left arm weakness due a right frontal cerebral infarct that occurred 2 weeks ago. She has hypertension and dyslipidemia. Current medications are aspirin, chlorthalidone, and atorvastatin.
On physical examination, vital signs are normal. Left arm shows 4/5 muscle strength throughout, with increased tone in the elbow and finger flexors. Cardiac and peripheral vascular examinations are normal.
LDL cholesterol level is 68 mg/dL (1.76 mmol/L). Serum creatinine level, basic metabolic profile, and aminotransferase levels are normal.
CT scan of the head shows a right frontal lobe infarct involving the cortical surface compatible with an embolic stroke. ECG shows sinus rhythm, left atrial enlargement, and left ventricular hypertrophy. Transthoracic echocardiogram shows an ejection fraction of 50% with no wall motion abnormalities, left atrial dilation, valvular regurgitation, or stenosis. Carotid duplex ultrasound shows less than 40% stenosis in both carotid arteries and normal flow in the vertebral arteries. Magnetic resonance angiogram of the brain shows no major arterial stenoses.
Which of the following is the most appropriate management?
A) Adding clopidogrel to aspirin
B) Changing aspirin to rivaroxaban
C) Prolonged ambulatory ECG
D) Transesophageal echocardiography
C) Prolonged ambulatory ECG
The patient had an embolic stroke of undetermined source (ESUS), based on the infarction on the cortical surface without an alternative source of emboli identified (e.g., large artery atherosclerosis or atrial fibrillation). Prolonged cardiac rhythm evaluation with ambulatory cardiac ECG or an implantable loop recorder may be positive for atrial fibrillation in approximately one third of patients with ESUS and dictate a change in therapy. The patient has several predictors of finding atrial fibrillation, including left atrial enlargement and hypertension.
Dual antiplatelet therapy (DAPT) with aspirin and clopidogrel (Option A) started 12 to 24 hours after stroke onset and continued for 21 to 90 days in patients with TIA and minor ischemic stroke results in a small but significant reduction in risk of recurrent stroke at 90 days. This patient has missed the window for DAPT and more than likely has an embolic rather than large vessel ischemic stroke; therefore, DAPT is not indicated.
Changing aspirin to rivaroxaban (Option B) is not appropriate because direct-acting anticoagulants have not been established as effective and safe therapy in patients with ESUS. In two clinical trials examining rivaroxaban or dabigatran versus aspirin in ESUS, aspirin was equivalent for stroke prevention and was associated with fewer hemorrhagic complications. Further trials are ongoing in patients with a higher suspicion for atrial fibrillation.
Transesophageal echocardiography (TEE) (Option D) can be considered in younger patients without risk factors in whom a transthoracic echocardiogram was negative for a source of emboli or in patients with a high suspicion for high-risk embolic sources, such as bacterial endocarditis or an atrial myxoma. TEE is a low-yield diagnostic test in an older patient in sinus rhythm with multiple risk factors for stroke.
Name the father of modern cereal
John Harvey Kellogg, MD
Kellogg opened his Chicago mission in 1893. It “offered a free medical dispensary, free baths, free laundry, an evening school for Chinese, and a visiting nurse’s service.” Kellogg’s Sanitarium Health Food Company provided special foods as well. Additionally, a penny lunch service was instituted: a bowl of bean soup with zwieback crackers, offered for a penny, went to an average of 500-600 people a day.
Like Sylvester Graham, whose name also lives on in food form (i.e., graham crackers), Kellogg believed in foods that would not excite the passions. This meant vegetarianism. It also meant combatting what was considered the debilitating scourge of masturbation.
A 75-year-old man is hospitalized with sepsis secondary to community-acquired pneumonia. He has been otherwise well before hospital admission and was taking no medications.
On physical examination, temperature is 39.4 °C (102.9 °F), blood pressure is 90/52 mm Hg, pulse rate is 110/min, and respiration rate is 16/min. Oxygen saturation is 92% using a nonrebreathing mask. Cardiac examination reveals tachycardia. Bilateral basilar pulmonary crackles are noted.
Laboratory studies:
Activated partial thromboplastin time -55 s
D-dimer - 2.8 μg/mL (2.8 mg/L)
Hemoglobin - 9.1 g/dL (91 g/L)
Leukocyte count - 14,000/μL (14 × 109/L)
Platelet count - 55,000/μL (55 × 109/L)
Prothrombin time - 19 s
Fibrinogen - 105 mg/dL (1.05 g/L)
Peripheral blood smear is shown.

Cultures are collected. Fluid resuscitation is provided with 0.9% saline, and broad-spectrum antibiotics are initiated.
Which of the following is the most appropriate initial treatment for the coagulopathy?
A) Eculizumab
B) Prednisone
C) Therapeutic plasma exchange
D) No additional treatment
D) No additional treatment
He has disseminated intravascular coagulation (DIC), which has been triggered by sepsis. DIC is a systemic process with widespread and inappropriate activation of coagulation and concomitant fibrinolysis. In acute DIC, coagulation factors and platelets are rapidly consumed, leading to bleeding, organ dysfunction, and microangiopathic hemolytic anemia manifesting as schistocytes on the peripheral blood smear (see figure in Stem). Normal compensatory mechanisms are unable to keep up with the consumption of many blood components, resulting in depletion of platelets and coagulation proteins. Patients may have bleeding resulting from lack of available procoagulant factors in addition to large amounts of fibrin degradation products released from accompanying fibrinolysis, which interferes with normal platelet function and fibrin formation. Bleeding can often be seen at mucosal sites and areas of procedures (e.g., venous catheters). Organ dysfunction, including kidney and liver impairment, is also common. Laboratory findings in acute DIC include prolongation of the prothrombin and activated partial thromboplastin times, thrombocytopenia, low fibrinogen level, and markers of fibrinolysis such as an elevated D-dimer. Sepsis is the most common cause of acute DIC. Treatment focuses on addressing the underlying condition. Platelet transfusions, cryoprecipitate, and fresh frozen plasma are provided as needed for bleeding manifestations.
aHUS, ITP, AIHA, or TTP are not associated with coagulation abnormalities.
A 58-year-old woman is evaluated for follow-up of chronic insomnia. She has participated in cognitive behavioral therapy for insomnia; however, she continues to have difficulties maintaining sleep. After a discussion of risks and benefits and shared decision making, the patient has opted for a limited course of pharmacologic therapy for her insomnia. She has no other medical problems and takes no medications.
Which of the following is the most appropriate treatment?
A) Diphenhydramine
B) Doxepin
C) Trazodone
D) No pharmacologic treatment
B) Doxepin
Chronic insomnia is diagnosed by the presence of symptoms that (1) cause substantial functional distress or impairment; (2) occur at least 3 nights per week for at least 3 months; and (3) are not associated with other sleep, medical, or mental disorders. Multiple guidelines recommend cognitive behavioral therapy for insomnia (CBT-I) as the preferred therapy for chronic insomnia because of its effectiveness and safety. However, some patients will not improve with CBT-I, and others will decline to participate. In those situations, short-term pharmacologic therapy can be considered. Physicians should engage in a thorough shared decision-making process to decide whether to initiate pharmacologic therapy in patients with refractory insomnia. Pharmacologic therapy can be associated with harms, including daytime drowsiness, increased risk for falls and hip fracture, and medication-related hallucinations. The 2020 guideline from the U.S. Department of Veterans Affairs and U.S. Department of Defense recommends low-dose doxepin or nonbenzodiazepine benzodiazepine receptor agonists (e.g., zolpidem, zaleplon, eszopiclone) in this situation. Low-quality evidence shows improvement in subjective sleep latency, total sleep time, and sleep quality outcomes in patients receiving doxepin compared with placebo. For short-term use, there does not seem to be an increase in adverse events in patients taking doxepin compared with placebo.
The use of antihistamines, such as diphenhydramine (Option A), is not recommended for chronic insomnia. Antihistamines are often used off-label as a sleep aid due to their sedating properties, but there are no data on their efficacy in treating chronic insomnia. In addition, because of their well-known anticholinergic effects, antihistamines may be associated with adverse drug events, particularly in elderly patients.
Trazodone (Option C) is not recommended for patients with chronic insomnia. Data from a systematic review showed that trazodone improved the subjective measure of sleep quality compared with placebo; however, there was no difference in objectively measured sleep onset latency, total sleep time, or waking after sleep onset.
Pharmacotherapy for chronic insomnia is indicated in patients who have not responded to nonpharmacologic therapies, such as sleep hygiene and cognitive behavioral therapy, after a shared decision-making discussion of the risks and benefits. This patient has not responded to nonpharmacologic therapy and meets the criteria for pharmacotherapy (Option D).
A 52-year-old woman is evaluated at a follow-up visit. Dermatomyositis was diagnosed 4 weeks ago; she was positive for anti–Mi-2 antibodies. Prednisone has improved heliotrope and photosensitive rashes and proximal muscle weakness. She is currently asymptomatic. Current medication is prednisone, 60 mg/d. She is participating in physical therapy.
On physical examination, vital signs are normal. There is no rash. Muscle strength is normal.
Serum creatine kinase level is 200 U/L, decreased from 520 U/L 1 month ago.
Results of screening colonoscopy, mammography, and cervical cancer screening are all normal.
Which of the following is the most appropriate treatment?
A) Add hydroxychloroquine
B) Add methotrexate
C) Add rituximab
D) Continue current therapy
B) Add methotrexate
This patient has classic clinical and laboratory features of dermatomyositis with myositis-associated autoantibodies and no evidence of associated malignancy or other complications. In particular, the presence of anti–Mi-2 antibodies predicts a good prognosis with a low risk for interstitial lung disease and cancer. Her symptoms have completely resolved with an initial course of oral prednisone, typically initiated at 1 mg/kg/d. Combination therapy with glucocorticoid-sparing agents is important for maintaining a clinical response and for minimizing glucocorticoid adverse effects in patients with dermatomyositis. Initiation of methotrexate or azathioprine at diagnosis or after an early initial response to glucocorticoids is the most appropriate next step to achieve long-term disease control and to allow effective tapering of the prednisone dose. Intravenous immune globulin can be added as first- or second-line treatment for patients with an inadequate response to initial combination therapy or with more severe disease. There is no guidance for optimal duration of therapy, but in the absence of flares, most patients can discontinue treatment in 9 to 12 months. Physical therapy may help maintain muscle function and should be used in all patients.
A 64-year-old man is hospitalized for right-sided weakness and slurred speech of 24 hours' duration. He has hypertension and dyslipidemia. Current medications are aspirin and high-intensity atorvastatin.
On physical examination, blood pressure is 190/88 mm Hg and oxygen saturation is 98% with the patient breathing ambient air. The remaining vital signs are normal. Abnormal physical examination findings are confined to right facial weakness and right arm and leg pronator drift. National Institutes of Health Stroke Scale score is 3.
ECG is normal. Serum creatinine level is 0.9 mg/dL (79.6 µmol/L), and cardiac biomarkers are negative.
CT scan of the head shows a left frontal infarction. CT angiogram shows 80% stenosis of middle cerebral artery.
Which of the following is the most appropriate immediate treatment?
A) Chlorthalidone
B) Furosemide
C) Intracranial stenting
D) Lisinopril
E) No additional intervention or treatment
E) No additional intervention or treatment
In patients not eligible for thrombolytic therapy, the blood pressure (BP) threshold for initiating antihypertensive therapy is greater than 220/120 mm Hg; reduction of BP by 15% during the first 24 hours may then be reasonable.
One of the oldest surgical procedures known to humanity and refers to a surgical procedure in which a circular piece of bone is drilled and excised, most commonly from the human skull.
Trephination, also known as trepanning, trepanation or burr holing